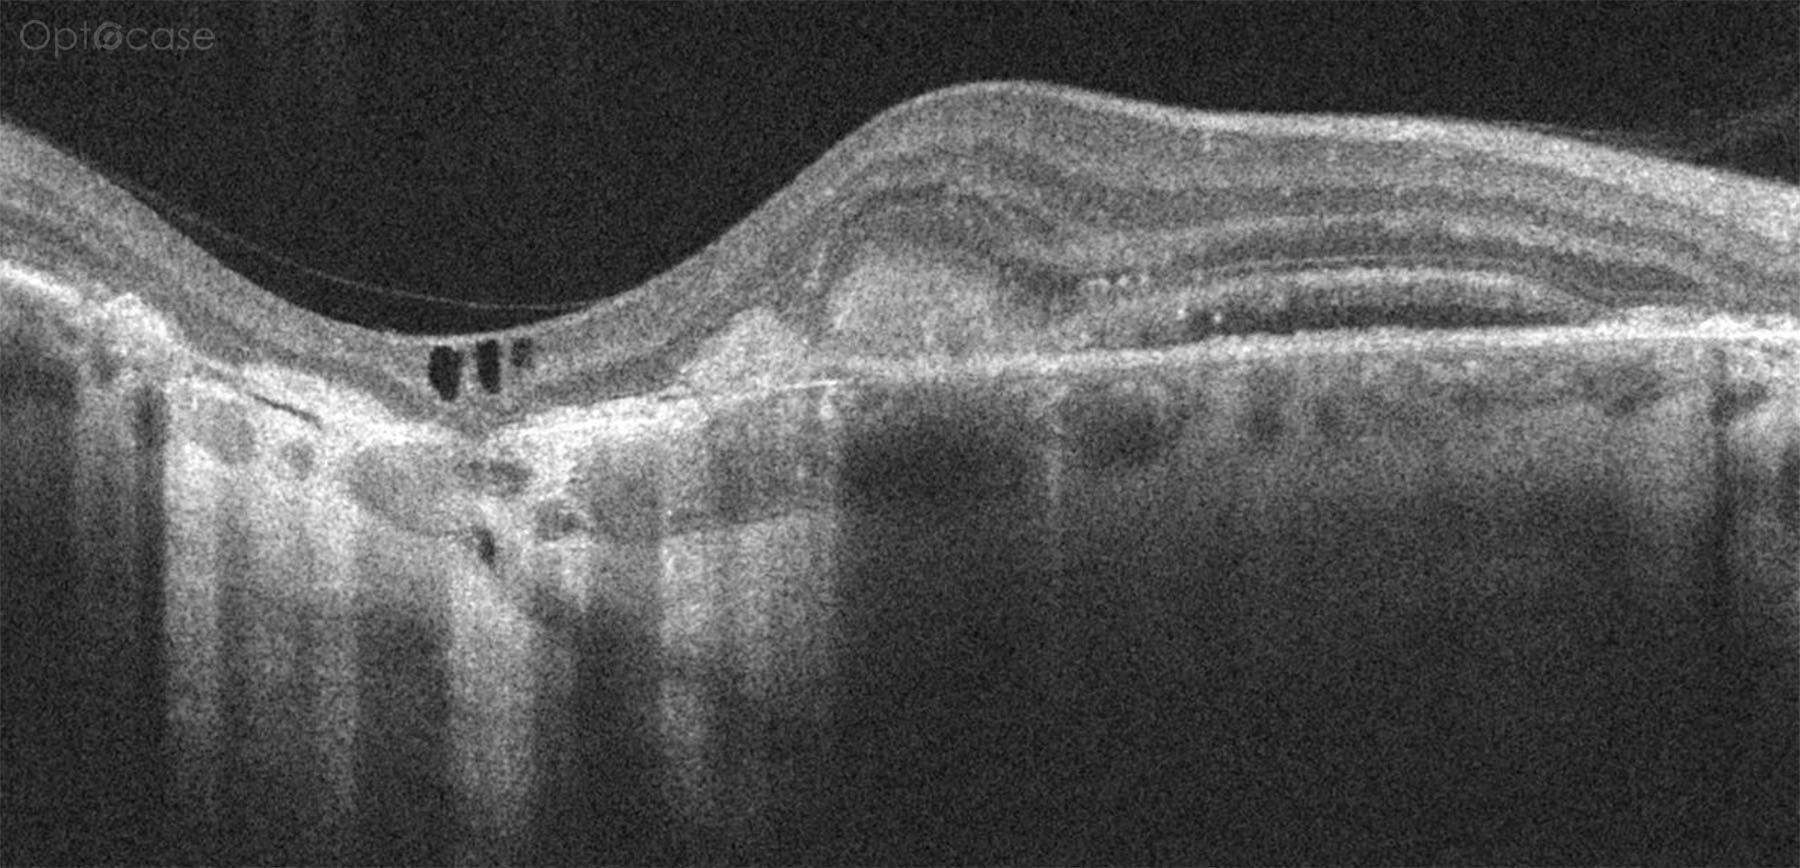
Tip #244

A 44-year-old presents with distortion. Why?
Analysis
Here we can see there is significant retinal thinning to the left of the image. In the retina there are some intraretinal cysts. Below the area of retinal thinning there is excessive hyperreflectivity consistent with an area of geographic atrophy. To the right of the image (nasally) there is a small area of subretinal fluid.
This patient was diagnosed with a CNV secondary to Ocular Histoplasmosis.
In this tip's accompanying 10 min. video, we'll review:
- The differential diagnosis of CNV
- The pathogenesis of OHS
- Some inflammatory conditions that may present with retinal scarring.

OCT Tip
In a patient with a CNV, look at the mid-periphery and look for punched out lesions consistent with ocular histoplasmosis
Not receiving our tips yet? Subscribe to receive them straight to your inbox.